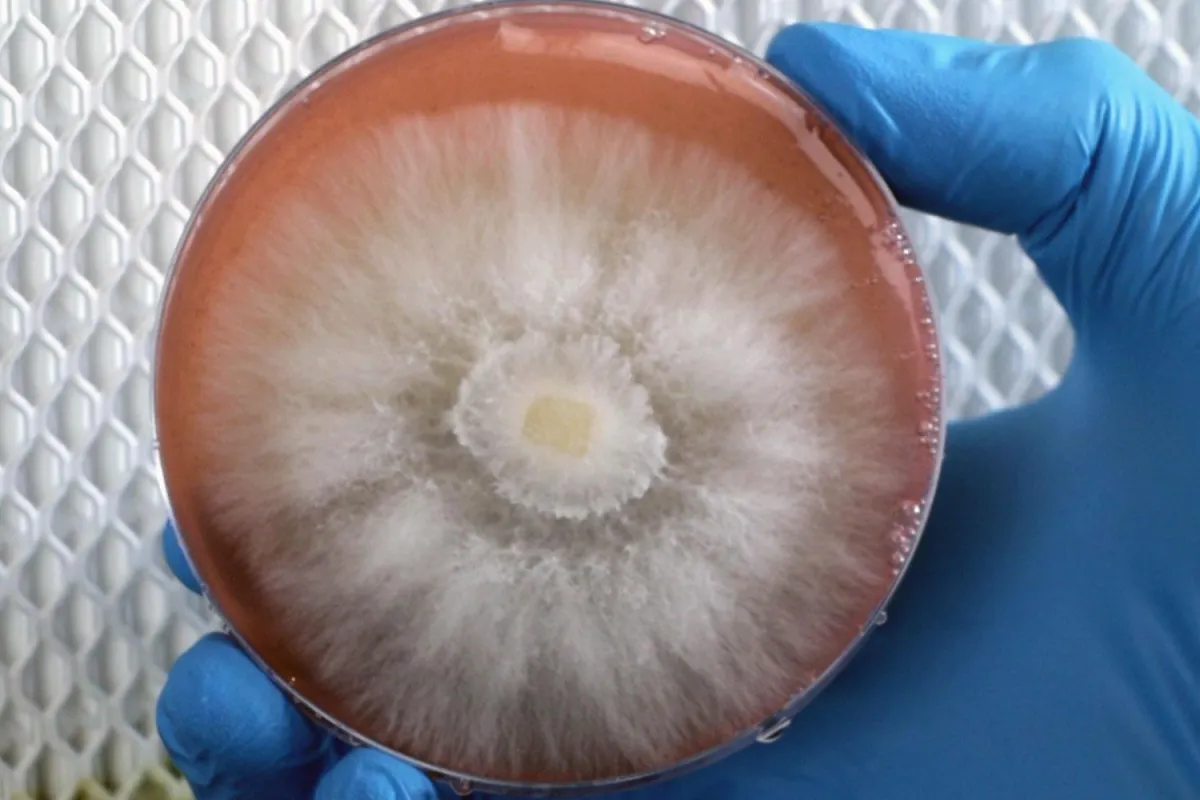

Besoin d'aide ? [email protected]
Myco Pro
Une formation pour les myciculteurs passionnés qui veulent vivre de la myciculture, grâce à des stratégies éprouvées sans prendre de risque, et sans être bloqués par le manque de connaissances ou de ressources.
Accès à 35h de formation à vie
Mise à jour de la formation gratuite à vie
Coaching commun de 2 heures toutes les deux semaines pendant deux ans
Accès à vie au cercle privé des myciculteurs
Vous aimeriez vivre confortablement de la culture des champignons mais..
Que vous débutiez ou souhaitiez perfectionner votre approche, vous ne savez pas par où commencer ?
Vous n'êtes pas précis dans les différentes étapes et phases de production ?
Vous voulez maîtriser parfaitement les paramètres de culture pour maximiser vos récoltes ?
Vous rencontrez des obstacles à fabriquer rapidement des substrats efficaces et productifs pour vos champignons ?
Je comprends tout à fait, je passe par les mêmes étapes moi aussi ...
Il y a moins de 50 personnes en France qui sont véritablement Myciculteur Professionnel.
Vous voulez maîtriser parfaitement les paramètres de culture pour maximiser vos récoltes ?
Vous rencontrez des obstacles à fabriquer rapidement des substrats efficaces et productifs pour vos champignons ?
Les champignons : l'or de demain pour ceux qui savent les produire.
Il y a quelques années, j'étais maraîcher et je cultivais des légumes de grande qualité dans les plaines du Gers 🥕🌱. Les clients étaient très contents des produits que nous leur livrions et ils nous remerciaient par leur fidélité ❤️.
Un jour, dans les champs, quelques jours après une pluie torrentielle, de nombreux champignons gris apparurent sur un tas de copeaux de bois. Non initié à l'époque, je ne reconnus pas tout de suite les fameux pleurotes en huître 🍄. Ce sont des champignons lignivores qui poussent sur du bois, et ils s’avèrent être de très bons champignons comestibles 🍽️.
Après nous être régalés en mangeant une partie de notre récolte fongique 😋, nous avons décidé de proposer l'autre partie à la vente. Nous en avons mis dans des paniers pour les AMAPs 🧺, et un client restaurateur s’est montré immédiatement intéressé et les a achetés à un bon prix (je crois que c’était autour de 15 € pour un peu moins d'un kilo 💸).
Quelques semaines après, le restaurateur nous a recontactés pour savoir si d'autres champignons avaient poussé sur le tas de copeaux 🌱. Il était prêt à prendre tout ce que la nature avait donné. Hélas, le temps s’était asséché, et les pleurotes n’étaient pas réapparus ☀️.
Avec l'intérêt que notre restaurateur manifestait pour nos champignons, j'ai commencé à m'intéresser à la culture des champignons 📚. Je n'avais cependant pas la moindre idée de la manière dont on cultivait ces organismes fongiques, ni plantes ni animaux... et encore moins comment on pouvait réaliser une culture commerciale 🤔.
À l'époque, je n'ai pas su répondre aux besoins de ce restaurateur ni à ceux des clients des AMAPs venus en personne à notre ferme 🚜. Je n'avais nulle part où me former correctement.
Ainsi, je me suis entrainé à la culture des champignons pendant 5 ans 🍄, et durant tout ce laps de temps, les gens n'ont cessé de me demander si je pouvais leur vendre ma production personnelle. Que ce soit dans ma ville ou sur internet 🌍, les demandes sont de plus en plus pressantes et nombreuses.
Aujourd’hui, cela fait dix mois que j’ai lancé ma ferme à champignons 🍄. Ma production monte en puissance (environ 140 kilos par mois actuellement, avec un maximum autour de 200–220 kilos) et tout est déjà vendu. Je réfléchis même à agrandir la ferme pour répondre à la demande 🚀. Je n’ai pas cultivé uniquement ce que je voulais produire : j’ai mis en lien ce que j’aime cultiver et ce que mes clients aiment acheter. Résultat : une production sécurisée et des débouchés avant même la récolte.
Aujourd'hui, l'opportunité commerciale est là, mais pour moi, elle est dépassée par bien d'autres motivations. En cultivant les champignons, j'ai découvert bien plus qu'une simple source de revenus : c'est une passion bien sûr, mais aussi un lien avec la nature et un chemin vers l'autosuffisance de mon territoire. Au-delà des aspects économiques, c'est un engagement envers une alimentation saine et durable pour les autres 🌿. C'est aussi l'occasion de créer du lien social et de partager cette aventure avec d'autres passionnés. 😊
Voici ce que je vous propose pour vous accompagner au mieux.
Depuis la première année d'existence de cultiver-les-champignons.com 🌐, vous n'avez cessé de me réclamer une formation professionnelle 🍄.
Cela a pris du temps (4 ans) ⏳, car j'ai longtemps hésité à vous donner toutes ces informations qui m'avantageaient considérablement sur le marché de la myciculture. Mais la formation Myco Pro est enfin là 🎉, prête à vous transmettre les connaissances et l'expérience que j'ai acquises au fil des années, en côtoyant des myciculteurs professionnels et en étudiant des systèmes de production venant de l'étranger 🌍.
Elle vous permettra de monter une véritable ferme à champignons 🚜, de la création de l'entreprise à la réalisation de l'outil de production, en passant par la fabrication des substrats, la fructification des champignons 🍄 et leur vente 💰.
La formation est adaptée aux myciculteurs avancés 🌟, sans pour autant exclure les débutants complets 🎓. En effet, j'ai inclus dans cette offre les formations MYCO START (cliquez pour voir le programme) et MYCO LABO (cliquez pour voir le programme), pour vous offrir un parcours d'apprentissage sur mesure 📚✨.
Pour ceux qui ne sont pas intéressés par une formation structurée 🎓, je vous partage ici les meilleures chaînes YouTube 📺 (en anglais) pour apprendre à monter votre ferme à champignons 🍄. Cela vous donnera une idée de ce qui va se passer en France 🇫🇷, d'ici quelques années, voire quelques mois... alors soyez dans les starting blocks ! 🏃♂️🏃♀️😉
Ce que je vous apporte
Des milliers d’heures de tâtonnement et d'expérimentation en moins.
Des milliers d’euros économisés sur les erreurs de production, sur les erreurs de choix du matériel de culture et sur les erreurs de souches de champignons.
Des connaissances précieuses pour vous établir professionnellement avant et devant la concurrence.
Et ce n’est pas tout ! Des séances de coaching communes de 2h toutes les 2 semaines vous attendent avec moi et les autres élèves, pour que je puisse répondre aux interrogations spécifiques de chacun.
En supplément : Des champignons dès votre première récolte avec la formation Myco Start.
En deuxième supplément : Du mycélium pur dès vos premières manipulations avec la formation Myco Labo.
Quels types de champignons et de milieux de culture cette formation permet-elle de réaliser ?
Dans la formation Myco Pro, vous apprendrez à gérer de gros volumes de plusieurs types de milieux, de manière efficace pour obtenir des résultats conséquents.
Tous d'abord les substrats de fructification à partir de divers bases :

Base Sciure

Base Pellet de bois

Base Paille
Et puis les milieux de laboratoire, que vous pourrez choisir de produire ou pas, en fonction de l'itinéraire technique, plus ou moins autonome, que vous choisirez :
Gélose

Culture liquide

Mycélium sur grain
Ensuite, les types de champignons que vous apprendrez à faire pousser sont des champignons lignivores. Ce sont les organisme qui se nourrissent de paille, de sciure ou encore de pellet de bois. C’est la plus grande catégorie de champignons cultivables !
Les cours pratiques de production commerciale que vous suivrez portent sur 5 espèces :

Pleurote en Huître

Crinière de Lion

Shiitaké

Pholiote du Peuplier

Pleurote de Panicaut
Les cours théoriques sont bien sûr applicables commercialement à ces espèces de pleurotes et champignons lignivores :

Pleurote Black Pearl

Champignon Châtaigne

Pleurote pulmonaire

Réishi

Pleurote Jaune

Maitaké

Pleurote Rose

Pleurote de l'Orme
(cliquez pour afficher le menu déroulant des modules)
Cours 1.1 : L’histoire de la culture des champignons (évolution des pratiques):
Les premières mentions historiques de la culture des champignons sont explorées, avec un focus la transition des méthodes traditionnelles aux techniques modernes, ainsi que sur les perspectives pour l’avenir de la myciculture.
Cours 1.2 : Biologie et cycle de vie des champignons (Rappel) :
Un rappel sur la biologie des champignons, avec une distinction entre champignons, plantes et animaux. Les étapes du cycle de vie, de la sporulation à la fructification, sont expliquées, ainsi que les différences entre la reproduction sexuée et asexuée. Des exemples d’espèces cultivables et de leurs habitats sont également fournis.
Cours 1.3 : Le cycle de culture des champignons (vue d’ensemble des itinéraires techniques) :
Présentation des itinéraires techniques de production de champignons, avec une distinction entre les méthodes professionnelles et domestiques. Les avantages des substrats supplémentés par rapport aux substrats bruts sont également discutés.
Cours 2.1 : L’entreprise du myciculteur :
Présentation des étapes pour devenir un myciculteur professionnel, incluant la création de l’entreprise, l’inscription à la chambre d’agriculture, à la MSA, ainsi que les aspects réglementaires à connaître.
Cours 2.2 : Aspects juridiques et fiscaux :
Un guide sur le choix du statut juridique pour une entreprise de myciculture, avec un aperçu des différents régimes fiscaux et des avantages et inconvénients de chaque statut.
Cours 2.3 : Aspect économique : Business plan fongique :
Explication de l’importance d’un business plan en myciculture, avec une analyse de la demande pour différents types de champignons, des objectifs de production, du budget de démarrage, et des marges prévisionnelles.
Cours 2.4 : L’état d’esprit d’un myciculteur professionnel :
Les qualités essentielles à adopter pour réussir en tant que myciculteur professionnel, telles que l’organisation et la résilience. L’importance d’une bonne hygiène de vie et d’une planification adéquate est également abordée.
Cours 2.5 : Collecte des données :
Les différentes données à collecter, telles que le temps de travail, les phases de culture, les paramètres environnementaux, et les rendements, afin d’améliorer la productivité.
Cours 3.1 : Trouver un endroit pour son projet :
Comment trouver un local pour établir sa ferme à champignons, avec un focus sur les critères à prendre en compte dans le cahier des charges.
Cours 3.2 : Agencer sa ferme à champignons :
Les différentes options d’agencement des espaces de travail sont explorées, avec des exemples pratiques et des conseils pour optimiser l’utilisation de l’espace en fonction des besoins de production.
Cours 3.3 : Espace de fructification :
Le rôle de l’espace de fructification est détaillé, avec des conseils pour sa conception, l’aménagement nécessaire, et les équipements à utiliser pour maximiser la production.
Cours 3.4 : Espace d’incubation :
Description de l’espace d’incubation, ses objectifs, et les étapes pour sa construction. Le matériel requis et des exemples concrets d’aménagement sont fournis.
Cours 3.5 : Espace Labo (stérilisation/inoculation) :
Les critères pour aménager un laboratoire sont expliqués, avec une attention particulière aux flux d’air et aux équipements nécessaires pour les processus de stérilisation et d’inoculation.
Cours 3.6 : Espace fabrication/stockage substrat :
Les spécificités de l’espace dédié à la fabrication et au stockage des substrats sont abordées, avec des conseils sur le choix du matériel et sur des configurations optimales.
Cours 3.7 : Espace chambre froide / Préparation des commandes :
Les bonnes pratiques pour aménager une chambre froide et un espace de préparation des commandes sont présentées, en détaillant les exigences en termes de matériel et d’organisation.
Cours 3.8 : Espace de recapture du rendement :
Explication de l’utilité de cet espace pour l’optimisation des rendements hors chambre de fructification. Des exemples d’aménagement et des recommandations sur le matériel sont proposés.
Cours 3.9 : DIY Ensacheuse :
Instructions détaillées pour construire une ensacheuse, en choisissant les pièces adéquates, avec des options de personnalisation et les étapes de fabrication.
Cours 3.10 : DIY Super-Pasteurisation (Pasteurisateur vapeur) :
Les étapes de construction d’un pasteurisateur vapeur, avec des conseils sur le choix des pièces, les options et le fonctionnement optimal.
Cours 3.11 : DIY Système de ventilation et de gestion de l’humidité :
Conception et fabrication d’une ventilation optimisée pour les pièces de fructification avec gestion de l’humidité et de l’évapotranspiration des champignons pour optimiser les conditions de culture.
Cours 4.1 : Les ITK pro et les compétences à acquérir :
Vue d’ensemble des différents itinéraires techniques (ITK) utilisés en myciculture, et des compétences spécifiques à acquérir pour chaque processus.
Cours 4.2 : ITK Laboratoire (Mycothèque & Gélose) :
Les précautions à prendre pour l’utilisation d’une mycothèque et les étapes pour ensemencer et incuber des géloses à partir de cette dernière.
Cours 4.3 : ITK Expansion (Culture liquide) :
Les étapes pour ensemencer une culture liquide à partir de géloses, avec des conseils sur la gestion des incubations et le passage à la phase suivante.
Cours 4.4 : ITK Expansion 2 (Mycélium sur grain) :
Préparation du mycélium sur grain, avec des détails sur la cuisson, l’humidification, la stérilisation, et le choix des grains. Instructions pour l’ensemencement des sacs et l’incubation du mycélium.
Cours 4.5 : ITK Fructification (Substrat de Fructification) :
Préparation des substrats de fructification, avec une comparaison entre paille, sciure et pellet. Explications sur les différents types de supplémentation, la stérilisation, et l’ensemencement des substrats.
Cours 4.6 : Contrôle du climat avancé, diagramme Mollier :
Utilisation du diagramme de Mollier pour gérer la température, l’humidité, et les flux d’air dans les environnements de culture.
Cours 4.7 : L’ITK résumé de ma ferme :
Résumé de l’itinéraire technique (ITK) de ma ferme, incluant un rétroplanning pour optimiser chaque phase de production.
Cours 4.8 : Nettoyage de la ferme :
Pourquoi et comment nettoyer la ferme à champignons, avec des recommandations sur le matériel nécessaire et des stratégies pour gérer les contaminations.
Cours 4.9 : Gagner du temps (goulot d’étranglement) :
Analyse des données temporelles pour identifier les goulots d’étranglement dans la production et des stratégies pour améliorer l’efficacité.
Cours 4.10 : Problèmes courants et leur gestion :
Liste des problèmes les plus fréquents à chaque stade de la production, avec des solutions concrètes et des ressources PDF pour la gestion de ces problèmes.
Cours 5.1 : Introduction à la production commerciale (choix des souches, rendement) :
Comment choisir les souches des diverses espèces en fonction de la saisonnalité, des itinéraires de culture et des objectifs commerciaux. Calcul du rendement moyen et rentabilité de chaque souche.
Cours 5.2 : Sourcer ses matières premières :
Liste des matières premières nécessaires (substrats, sacs, grains), avec des conseils pour les commander et identifier les sources de déchets organiques disponibles localement.
Cours 5.3 : Rétroplanning de la production sur un an :
L’importance de planifier la production sur un an, avec des conseils pour l’élaboration d’un planning, son utilisation, et les modifications nécessaires en cours de route.
Cours 5.4 : ITK de culture PRO Pleurote du Panicaut :
Les spécificités d’initiation pour cette variété de pleurote, avec des conseils sur la fructification, la récolte, la conservation, et la transformation.
Cours 5.5 : ITK de culture PRO Pleurote (gris, jaune, rose, pulmonaire) :
Présentation des techniques de culture professionnelle pour différentes variétés de pleurotes. Chaque variété a ses propres conditions de fructification, de récolte et de transformation.
Cours 5.6 : ITK de culture PRO Pholiote du peuplier :
Méthodologie de culture de la pholiote du peuplier, avec des conseils sur les conditions idéales de fructification, la récolte, et les meilleures pratiques pour la conservation.
Cours 5.7 : ITK de culture PRO Shiitaké :
Détails des étapes pour cultiver le shiitaké de manière professionnelle, avec la préparation des substrats, les cycles d’incubation, les techniques de fructification, et la gestion de la récolte pour un rendement optimal.
Cours 5.8 : ITK de culture PRO Crinière de Lion :
Explications sur la culture de la crinière de lion, avec des conseils sur la préparation des substrats, les conditions spécifiques de fructification, ainsi que des recommandations sur la récolte et la transformation.
Cours 5.9 : ITK de culture autres champignons :
Présentation des méthodologies pour tester et cultiver d’autres espèces de champignons. Un tableau récapitulatif des espèces commerciales cultivables est inclus pour aider au choix des souches.
Cours 6.1 : Vente et marketing fongique :
Introduction aux principes de la vente appliqués à la myciculture. Les stratégies pour améliorer ses compétences en vente, même si l’on ne se considère pas comme un bon vendeur, sont abordées.
Cours 6.2 : Trouver des clients : à qui vendre ? (Positionnement) :
L’importance de cibler ses clients avant de lancer une vente est discutée. Ce cours explore les différents types de positionnement commercial, les outils de vente disponibles, et les stratégies pour choisir ses clients ou se repositionner en cas d’erreur de ciblage. Il aborde également la manière de comprendre les besoins du marché, d’identifier des segments de clientèle prometteurs, et de se différencier des concurrents pour maximiser l'impact des efforts de vente et marketing.
Cours 6.3 : Gestion et préparation, stockage des commandes (ITK récolte et organisation) :
Guide sur la gestion des commandes, de la récolte à la préparation et au stockage. Les outils de gestion et les bonnes pratiques pour une organisation optimale sont présentés.
Cours 6.4 : Autres sources de revenus supplémentaires :
Exploration des revenus supplémentaires possibles pour un myciculteur, comme la vente de champignons séchés, de teintures, de kits de fructification, et d’autres fournitures mycologiques
Cours 6.5 : Norme de qualité, production (bio, alimentaire) :
Les normes de qualité à respecter dans la production de champignons, incluant la mention bio, le système HACCP pour la sécurité alimentaire, et d’autres normes spécifiques à la culture de champignons.
Cours 6.6 : Marketing digital et réseaux sociaux (communication) :
Stratégies de marketing digital spécifiques à la myciculture, avec une attention particulière à l’utilisation des réseaux sociaux pour promouvoir son activité, créer une communauté, et interagir avec des clients potentiels.
BONUS 1 : Créer des Kits de Culture :
Dans ce bonus, vous apprendrez à réaliser des kits de culture. Nous aborderons les étapes pour concevoir un kit attractif, de la production à l’emballage, ainsi que des stratégies efficaces pour commercialiser ces kits sur le marché. Une véritable opportunité pour diversifier vos sources de revenus tout en partageant votre passion pour la myciculture.
BONUS 2 : Valorisation des Substrats Usés :
Réalisation d'un lombricomposteur pour transformer vos restes de substrat en un lombricompost de qualité, commercialisable, pour augmenter les revenues de votre ferme.
Vous trouverez également des cahiers de cours avec une structure et des schémas, pour suivre facilement la formation.
N'attendez plus pour rejoindre la communauté
des cultivateurs de champignons d'exception !
Fermeture des inscriptions dans :
Myco Pro

Formation Myco Pro
Formation Myco Start + Myco Labo
Accès aux 3 formations en ligne à vie
(35h +15h +15h de formation)
Mise à jour des formations gratuite à vie
Coaching commun 2h toutes les semaines durant 2 ans
Accès à vie au Discord des myciculteurs pro (valeur inestimable)
Accès aux 85 replays du myco-coaching
Bonus de formation
Garantie 21 jours satisfait ou 100% remboursé
Garantie de résultat 2 ans
1197€
Paiement de 97€ x 13 mensualités disponible
Vous avez des questions sur la formation ?

Les avis de mes premiers élèves myciculteurs sur la formation Myco Pro
Olivier, 55 ans
Pierre



Les avis de mes élèves myciculteurs sur les formations Myco Labo et Myco Start
Clémentine
Victor, 27 ans
Sébastien
Fanny, 33 ans
Juliette, 29 ans
Loïc, 50 ans
Bernard, 79 ans
Hugues, 28 ans
Suzel, 29 ans
Gaël, 50 ans









La formation ne vous plait plus ?
Aucun souci !
Vous disposez d’une garantie de 21 jours après l’achat pour vous faire rembourser.
Pas besoin de me donner une raison.
Écrivez simplement à l’adresse suivante depuis votre adresse mail, avec laquelle vous avez payé la formation : [email protected]

Comment ça se passe après la commande ?
Cette formation est au format vidéo, c’est à dire qu’après le paiement vous recevrez tout de suite vos identifiants pour vous connecter au cours en ligne !
Après avoir cliqué sur « Commander » ci-dessus, vous serez redirigé vers une page Stripe, c'est un des moyens de paiement sur internet, les plus sécurisé au monde. Vous n’avez pas besoin d’avoir de compte Stripe pour finaliser la commande.
Stripe vous demandera certaines informations pour des raisons de sécurité, mais seule votre adresse mail me sera communiquée afin que je puisse vous envoyer vos identifiants pour accéder à la plateforme de formation et vous contacter par la suite !
Questions fréquemment posées
Oui, c'est une discipline très récente en France, et tout reste encore à créer. En apprendre la myciculture maintenant, vous vous placez en première ligne pour le marché de demain.
Oui, nous nous retrouvons en visio toutes les deux semaines, durant 2 heures avec les élèves de la formation pour répondre à vos questions spécifiques et partager les expériences et découvertes de chacun.
Oui! Il est tout à fait possible de suivre la formation en parallèle de votre activité actuelle. Sachant que vous aurez accès à la formation à vie, vous pouvez décider de la regarder à votre rythme, quand il vous plaira et depuis l'endroit que vous souhaitez.
Non, la formation est 100% en ligne. Vous pouvez la suivre à votre rythme, quand vous voulez et où que vous soyez.
Oui, les principes expliqués dans la formation sur la culture des champignons s’appliquent à tous les pays. Il vous suffira de choisir des champignons adaptés à votre climat, comme expliquer dans la formation.
Cultiver les champignons
Suivez-nous !